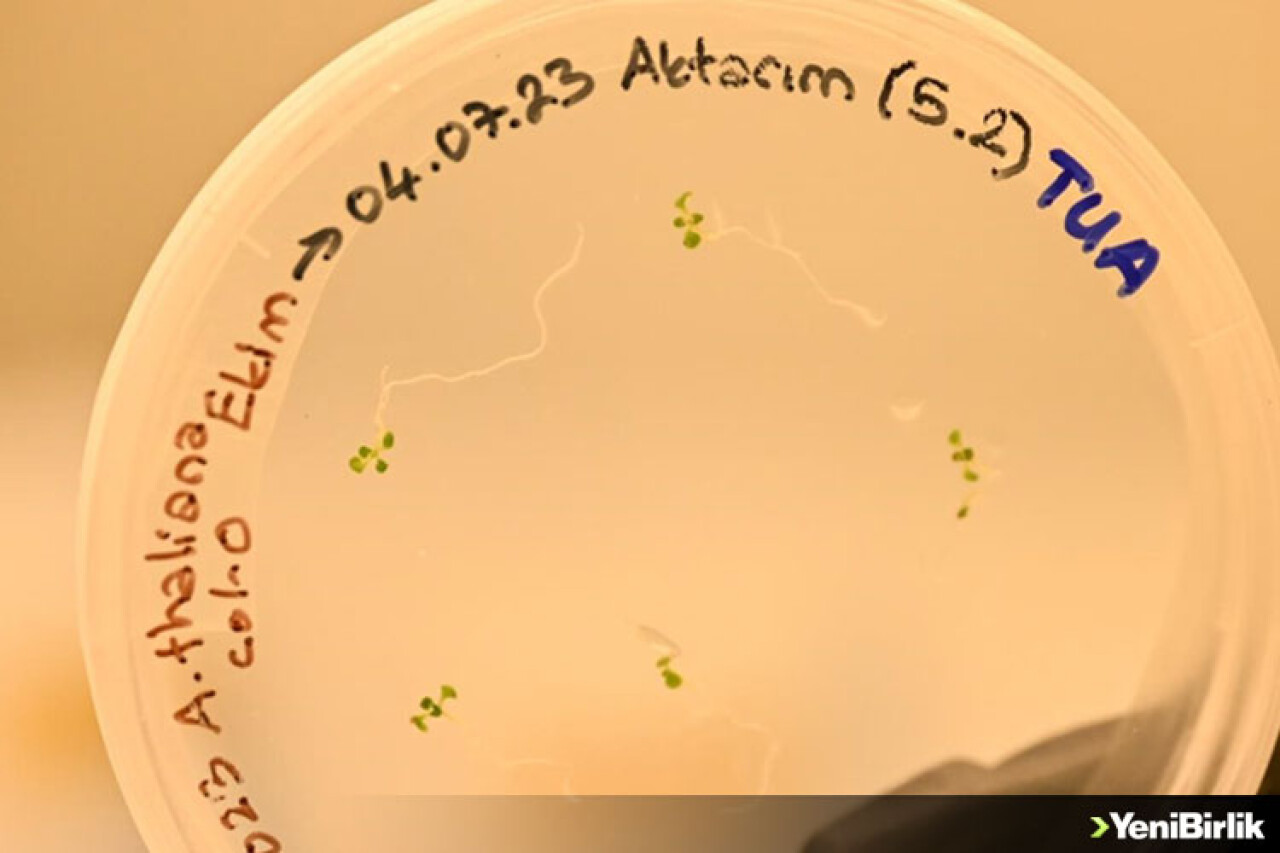
Türk bilim insanları uzayda bitki yetiştirecek

Cumhuriyet'in 100'üncü yılında gerçekleştirilecek uzay yolculuğunda, uzay yolcusu, üniversite ve araştırma kurumları tarafından hazırlanan 13 farklı deney gerçekleştirecek.
Türkiye Uzay Ajansı (TUA) ve TÜBİTAK Uzay Teknolojileri Araştırma Enstitüsü tarafından belirlenen deneylerden biri de "Mikro Yer Çekimi Altında Bitkilerde CRISPR Gen Düzenleme Verimliliğinin Araştırılması" başlıklı çalışma olacak.
Proje ile moleküler biyolojinin modern gen düzenleme tekniklerinden biri olan CRISPR tekniğinin mikro yer çekimi ortamında bitkiler üzerindeki etkinliğinin araştırılması, gen aktarımı ve genetik müdahalenin uzayda yapılıp yapılamayacağının test edilmesi amaçlanıyor.
Yıldız Teknik Üniversitesi Fen Edebiyat Fakültesi Moleküler Biyoloji ve Genetik Bölümü doktora öğrencisi Tuğçe Celayir'in yürütücülüğünü üstlendiği projede aynı bölümden Doktor Öğretim Üyesi Şenay Vural Korkut ile lisans öğrencisi Sıla Yigit ve Dünyadaki Mars Projesi (Mars on Earth Project (MoEP) kurucularından Ruha Uslu yer alıyor.
Laboratuvar çalışmalarına bu yılın mart ayında başlanan projenin bir sonraki safhasında, ilk Türk uzay yolcusu ile yer çekimsiz ortamdaki deneyler hayata geçirilecek.
Celayir, proje kapsamında uzay koşullarında bitkilerin üzerinde genetik müdahaleyi ve bu müdahalenin verimini araştırdıklarını söyledi.
Önceliklerinin uzay platformunda gerçekleşecek deneylerin moleküler seviyedeki analizlerinin gerçekleştirilmesi, proje kapsamında gönderilecek tüm materyallerin hazırlanması ve optimizasyonların gerçekleştirilmesi olduğunu belirten Celayir, "Projemizde bitkilere yapacağımız genetik müdahale ile sağlığını iyileştirmeye yönelik ileride yapılacak çalışmaları da destekleyecek şekilde ilk defa bir analizin yapılmasına odaklanıyoruz. Mikro yer çekiminde bu analiz yapılabilir mi? Bu uygulama yapılabilir mi? Aslında bu soruların cevaplarını arıyoruz." dedi.
"Bitkiler, yapay bir ekosistemde oksijen kaynağı sağlaması amacıyla kullanılabilir"
Projede kullandıkları model organizmanın "Arabidopsis thaliana" bitkisi olduğunu ve bu bitkiyi geniş kapsamlı kullanımı ve kısa çimlenme süresi nedeniyle seçtiklerini vurgulayan Celayir, bitki üzerinde planladıkları genetik müdahalenin daha önce hiç yapılmadığını, bu açıdan araştırmanın çığır açıcı olacağını ifade etti.
Celayir, sözlerini şöyle sürdürdü:
"Bu çalışma sonrası gelecekte gıda kaynağı olabilecek bitkiler, yapay bir ekosistem oluşturulması ve bu ekosistem içinde oksijen kaynağı sağlaması amacıyla da kullanılabilir. Geleceğin Mars kolonilerinin konuşulduğu günümüzde özellikle uzun süreli uzay görevlerinde hem astronotları destekleyecek bir ekosistem oluşturabilmek hem de oluşturulacak ekosistemde bu bitkilerin sağlığı için çalışmamız büyük önem taşıyor. Uzun süreli uzay görevlerinde karşılaştığımız en büyük problem, mikro yer çekimi ortamı ve yüksek dozda radyasyon maruziyeti. Bu nasıl astronotları olumsuz etkiliyorsa, uzay aracındaki bütün canlıları da etkiliyor. Böylesi uzun süreli uzay görevlerinde yaşamı devam ettirebilmek adına yapay bir ekosistem kurmamız gerekiyor. Bu ekosistem içinde kilit rol oynayan şey bitkiler çünkü fotosentez sayesinde oksijen üretebilir, gıda kaynağı olarak kullanılabilirler. Bu nedenle uzun süreli uzay görevlerinde bitkilerin sağlığı büyük önem taşıyor."
Bitkilerin yer çekimini algılaması
Bitkilerin bütün çevresel faktörleri algıladıkları gibi yer çekimini de algıladıklarını kaydeden Celayir, "Mikro yer çekiminde bugüne kadar yapılan diğer çalışmalara bakıldığında bitki kökleri farklılıklar gösteriyor, farklı yönlere saçılarak büyüme eğilimi gösteriyor. Ayrıca uzay deneylerinde topraklı kültürler yerine özel besi yerlerinin kullanıldığı görüyoruz. Bizimkinde de özel besi yeri üzerinde, bir nevi petri kaplarında bitkilerimiz büyümekte." diye konuştu.
Celayir, "Fırlatma tarihi henüz kesin değil ama 2023 yılının son çeyreğinde gerçekleşmesi planlanıyor. Daha sonra dünyaya geri gelen örneklerde analizlerimiz devam edecek ve projemiz tamamlanacak." ifadesini kullandı.